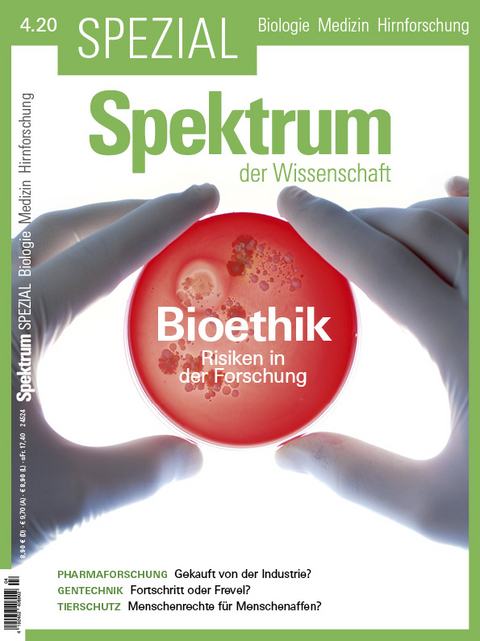
Spektrum Spezial - Bioethik

Spektrum Spezial - Bioethik
Risiken in der Forschung
Seiten
2020
Spektrum der Wissenschaft (Verlag)
978-3-95892-450-5 (ISBN)
Spektrum der Wissenschaft (Verlag)
978-3-95892-450-5 (ISBN)
- Titel ist leider vergriffen;
keine Neuauflage - Artikel merken
Forschung und Wissenschaft dienen alleine dem Wohl der Menschheit - so lautet zumindest das Kredo der modernen Naturwissenschaft und Medizin. Doch stimmt dies überhaupt? Denn auch Wissenschaftler sind fehlbare Menschen. Manchmal erliegen sie den Verlockungen aus Industrie und Wirtschaft - und manchmal wird der Vorwurf laut, ihr Forscherdrang schade mehr, als er nutze. Unser neues Spezial aus der Reihe Biologie, Medizin, Hirnforschung blickt hinter die Kulissen der Forschungslabore und berichtet aus dem interessanten Spannungsfeld zwischen Wissenschaft, Ethik und Kommerz. Aus dem Inhalt: Marionetten der Industrie?: Von Pharmaunternehmen bezahlte Forscher; Grüne Gentechnik: Gefragt und umstritten; Menschenrechte für Tiere?
| Erscheinungsdatum | 01.10.2020 |
|---|---|
| Reihe/Serie | Spektrum Spezial - Biologie, Medizin, Hirnforschung ; 4/2020 |
| Sprache | deutsch |
| Maße | 210 x 280 mm |
| Gewicht | 220 g |
| Themenwelt | Naturwissenschaften ► Biologie ► Humanbiologie |
| Schlagworte | Bestechlich • Biomedizin • Ethikkommission • Forscher • Grüne Gentechnik • Interessenskonflikte • Menschenaffen • Pharma • Rechte für Tiere • Tierwohl • Versuchstiere |
| ISBN-10 | 3-95892-450-6 / 3958924506 |
| ISBN-13 | 978-3-95892-450-5 / 9783958924505 |
| Zustand | Neuware |
| Informationen gemäß Produktsicherheitsverordnung (GPSR) | |
| Haben Sie eine Frage zum Produkt? |
Mehr entdecken
aus dem Bereich
aus dem Bereich
die Geschichte der Menschheit in 15 Porträts
Buch | Hardcover (2025)
DVA (Verlag)
CHF 39,20
produktiv sein ohne Stress – und mehr vom Leben haben
Buch | Softcover (2023)
dtv Verlagsgesellschaft
CHF 25,20
Veränderungen gehirngerecht gestalten
Buch | Softcover (2024)
Haufe (Verlag)
CHF 76,95


